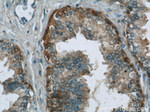
MIF Antibody in Immunohistochemistry (Paraffin) (IHC (P))

Search
Proteintech
MIF Polyclonal Antibody
{{$productOrderCtrl.translations['antibody.pdp.commerceCard.promotion.promotions']}}
{{$productOrderCtrl.translations['antibody.pdp.commerceCard.promotion.viewpromo']}}
{{$productOrderCtrl.translations['antibody.pdp.commerceCard.promotion.promocode']}}: {{promo.promoCode}} {{promo.promoTitle}} {{promo.promoDescription}}. {{$productOrderCtrl.translations['antibody.pdp.commerceCard.promotion.learnmore']}}
产品信息
20415-1-AP
种属反应
已发表种属
宿主/亚型
分类
类型
抗原
偶联物
形式
浓度
规格
纯化类型
保存液
内含物
保存条件
运输条件
产品详细信息
Immunogen sequence: GGSSEPCAL CSLHSIGKIG GAQNRSYSKL LCGLLAERLR ISPDRVYINY YDMNAANVGW NNSTFA (51-115 aa encoded by BC000447)
靶标信息
MIF (macrophage migration inhibitory factor) was one of the first cytokine activities to be discovered and was initially described as a T cell-derived factor that inhibits the random migration of macrophages (Weiser 1989). Recently, MIF was rediscovered as a pituitary hormone that act as the counterregulatory hormone for glucocorticoid action within the immune system (Bernhagen 1993, Mitchell 1995). MIF was released from macrophages and T cells in response to physiological concentrations of glucocorticoids. The secreted MIF counter-regulates the immunosuppressive effects of steroids on immune cell activation and cytokine production (Bucala 1998). MIF plays a critical role in the host control of inflammation and immunity.
仅用于科研。不用于诊断过程。未经明确授权不得转售。
生物信息学
蛋白别名: Delayed early response protein 6; DER6; epididymis secretory sperm binding protein; GIF; Glutathione-binding 13 kDa protein; Glycosylation-inhibiting factor; HGNC:7097; L-dopachrome isomerase; L-dopachrome tautomerase; Macrophage migration inhibitory factor; macrophage migration inhibitory factor (glycosylation-inhibiting factor); MGC107654; MIF; migration inhibitory factor; Phenylpyruvate tautomerase; unnamed protein product
基因别名: GIF; GLIF; MIF; MMIF
UniProt ID: (Human) P14174, (Mouse) P34884, (Rat) P30904
Entrez Gene ID: (Human) 4282, (Mouse) 17319, (Rat) 81683